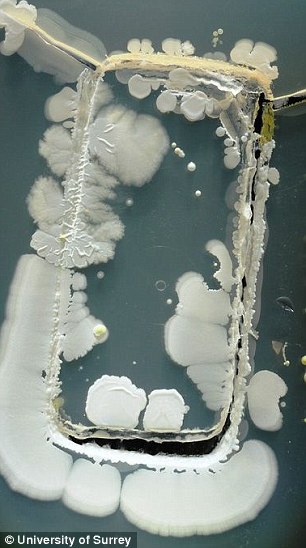

Британский таблоид DailyMail сообщает о исследовании Университета Суррея, которое показывает, что телефоны могут быть населены опасными бактериями.
Сегодня многие из нас не выпускают из рук телефоны — ещё в досмартфонную эпоху с их помощью можно было не только связаться с другими людьми, но и выйти в Интернет или воспользоваться медиавозможностями. Современные магазины приложений только добавляют новых функций, благодаря которым телефон становится незаменим для навигации, чатов, игр.
Часто используемые предметы — ключи, монеты, денежные банкноты — собирают грязь при использовании. Не являются исключениями и телефонные трубки. Во множестве случаев накапливаемые микроорганизмы относительно безвредны, они лишь являются следствием плохо вымытых рук или прикосновений к грязным поверхностям. Но бывают и опасные случаи, которые грозят сыпью на коже, заражениями крови и еды.
Британские учёные погрузили корпуса 30 телефонов в чашки Петри, содержавшие благоприятную для роста микроорганизмов среду. На фотографиях представлены результаты трёхдневного роста, а не содержимое мобильников на момент начала эксперимента.
В некоторых случаях встречались экземпляры золотистого стафилококка. Считается, что примерно пятая часть населения является переносчиком этой бактерии, которая сохраняется на коже и в слизистых оболочках верхних дыхательных путей. И эти люди не являются больными.
Но при нарушениях кожного покрова стафилококк может попадать в раны и вызывать инфекционные заболевания. Серьёзность варьируется от угрей, импетиго, фурункулов до пневмонии, менингита, сепсиса, инфекционно-токсического шока. Бактерия легко может распространяться по заражённым поверхностям от человека к человеку.
Другим опасным представителем фауны телефонов является Bacillus mycoides. Обычно эта бактерия обнаруживается в почве, то есть скорее всего аппарат или его пользователь недавно имели контакт с землёй.
Тесты показали, что в среднем мобильный телефон переносит в 18 раз больше бактерий, чем ручка слива в мужском туалете. Почти четверть тестируемых телефонов имела десятикратное превышение уровня заражения. Один экземпляр был настолько грязным, что простой разговор по нему грозил расстройством желудка.
Автор: FakeFactFelis